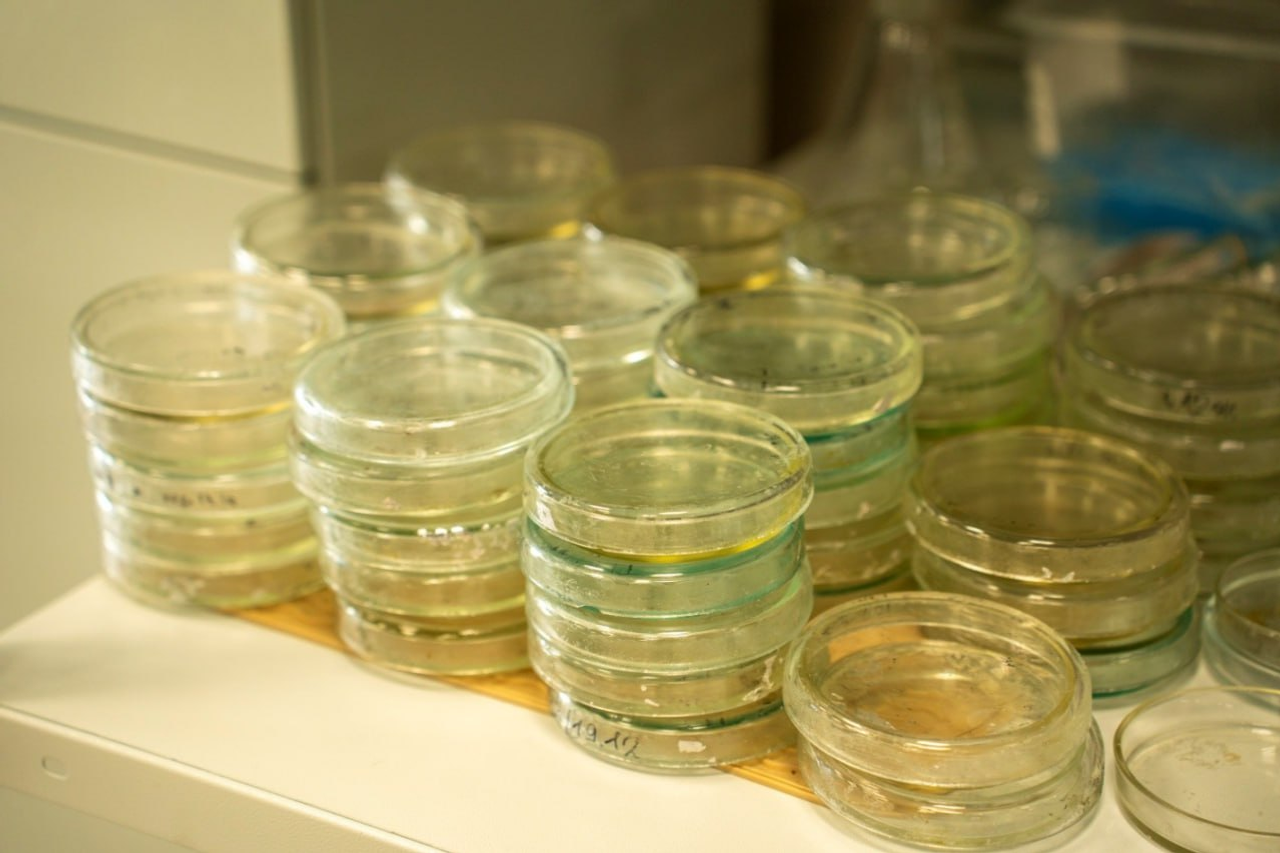
В Межвузовском кампусе Евразийского НОЦ открыли новую лабораторию биотехнологий

В Межвузовском кампусе Евразийского НОЦ открыли новую лабораторию биотехнологий
На площадке Межвузовского студенческого кампуса Евразийского НОЦ начала работу учебно-научная лаборатория биотехнологий «ИнноваБиоТех», созданная на базе Института природы и человека Уфимского университета науки и технологий.


Индустриальным партнёром проекта выступило научно-внедренческое предприятие «БашИнком».
Новая лаборатория стала очередным шагом в развитии исследовательской инфраструктуры и расширении кооперации между университетами и предприятиями. «ИнноваБиоТех» ориентирована на прикладные и фундаментальные исследования в сфере биотехнологий, направленные на повышение качества жизни, развитие устойчивого сельского хозяйства и создание функциональных продуктов питания.
– Открытие лаборатории „ИнноваБиоТех“ имеет высокую экологическую значимость для республики. Разработки, которые будут здесь вестись, непосредственно связаны со снижением антропогенной нагрузки на окружающую среду. В числе ключевых направлений - создание биопрепаратов для уменьшения пестицидной нагрузки на почвы, биологическая утилизация отходов сельского хозяйства. Особенно важно, что к исследованиям привлекаются молодые ученые. Это не только вклад в сохранение экологии региона, но и формирование современной экологической культуры будущих специалистов, — прокомментировал начальник Управления охраны окружающей среды Министерства природопользования и экологии Республики Башкортостан Рустам Каримов.
Новая лаборатория также будет заниматься формированием и пополнением коллекции высокоэффективных штаммов микроорганизмов для растениеводства и животноводства, повышением биодоступности жизненно важных микроэлементов, таких как йод и цинк, в пищевых продуктах.
– Открытие лаборатории «ИнноваБиоТех» на базе Межвузовского кампуса – это важный шаг к интеграции образовательного процесса с актуальными научными исследованиями и запросами реального сектора экономики. Мы уверены, что новая лаборатория станет точкой притяжения для молодых исследователей и усилит позиции УУНиТ как центра инновационного развития региона, – отметила руководитель лаборатории Мария Кузнецова.
Открытие «ИнноваБиоТех» в стенах Межвузовского кампуса интегрирует образовательный процесс с актуальной научной повесткой и запросами экономики. Ожидается, что площадка привлечёт молодых исследователей и укрепит позиции УУНиТ как центра инновационного развития региона.
Работа будет вестись в формате научно-исследовательских проектов, включая написание выпускных квалификационных работ, прохождение практик и реализацию совместных инициатив со студентами. Отдельное внимание планируется уделять участию в грантовых конкурсах и поддержке студенческих технологических стартапов.
– «ИнноваБиоТех» – пример того, как инфраструктура кампуса эффективно объединяет университеты, науку и индустриальных партнёров. Здесь студенты и молодые ученые работают над реальными технологическими задачами, участвуют в прикладных исследованиях и запускают собственные проекты. Такие инициативы формируют основу биотехнологического направления и усиливают роль кампуса как центра научно-технологического развития республики, – подчеркнул ректор УУНиТ, профессор Вадим Захаров.
Справочно:
Напомним, по поручению Президента Владимира Путина в России создается сеть современных кампусов. К 2030 году в стране должно появиться созвездие из 25 кампусов. Работу по данному направлению ведет Правительство Российской Федерации и Минобрнауки России. В настоящее время при поддержке национального проекта «Молодежь и дети» проектируются и строятся 24 таких студгородка. К 2036 году количество кампусов увеличится до 40.
Башкортостан стал одним из пилотных регионов России, где реализуется федеральный проект по созданию сети современных кампусов. Первая очередь Межвузовского студенческого кампуса Евразийского научно-образовательного центра в Уфе была открыта в феврале 2024 года.